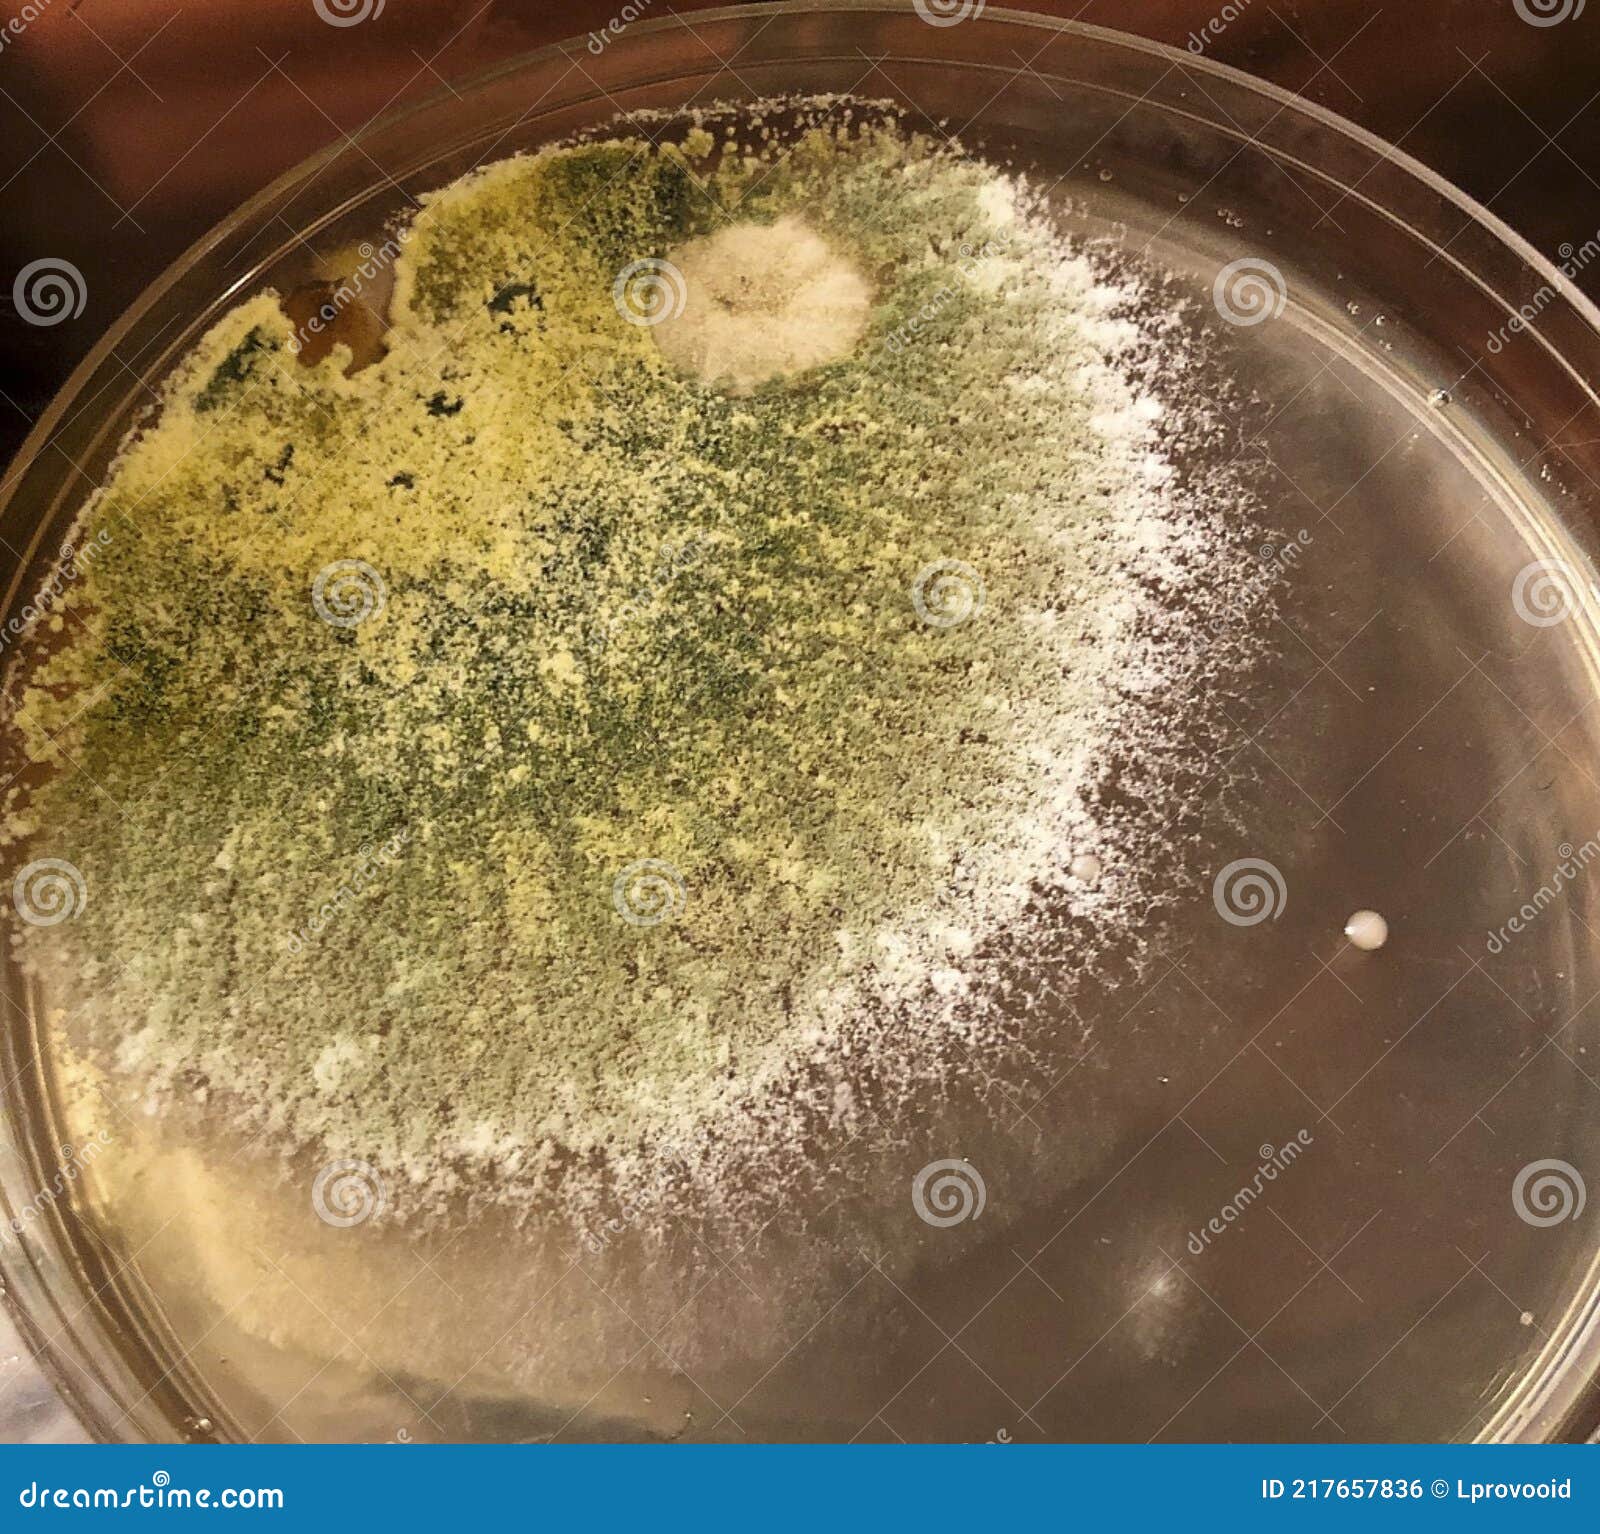

All is a visual journey into the world of what does black mold look like in a petri dish, with stunning images curated by natureflowsecret.edu.vn. You’ll find more to explore below.
what does black mold look like in a petri dish

We value your readership and your interest in what does black mold look like in a petri dish at natureflowsecret.edu.vn. Please comment with your thoughts, and we think you’ll find the related articles below quite interesting.
Posts: what does black mold look like in a petri dish
Categories: Collections
Author: natureflowsecret.edu.vn